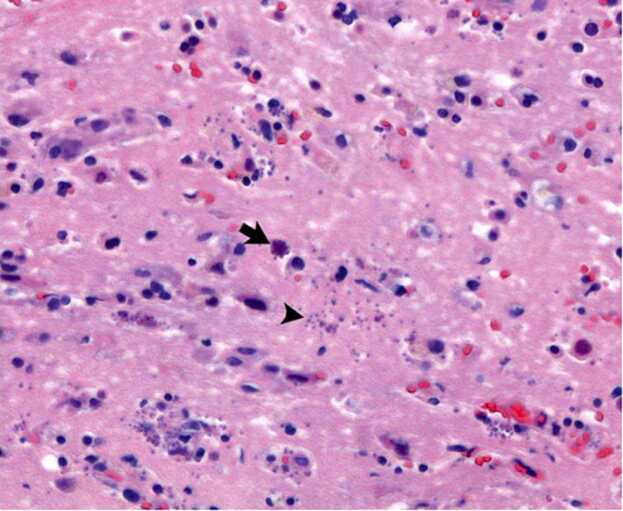
Fig. 3

Abstract
We report the case of a 78-year-old man with a past medical history of non-Hodgkin’s lymphoma s/p chemotherapy and Myasthenia Gravis on chronic mycophenolate mofetil (MMF), who presented with altered mental status and was found to have ring enhancing brain lesions. A brain biopsy revealed organisms consistent with Toxoplasma gondii. Cerebral toxoplasmosis has been rarely reported in patients with hematologic malignancies or in those receiving immunosuppressive agents. There needs to be a high degree of suspicion for T. gondii in HIV-negative individuals who are on immunosuppressants drugs including MMF.
Keywords: Toxoplasmosis, Toxoplasma encephalitis, Myasthenia Gravis, Mycophenolate mofetil
Introduction
Toxoplasmosis gondii is one of the world’s most ubiquitous parasites, largely because it possesses the capacity to infect a considerable number of mammalian and avian species. One of the most unique aspects of this protozoan parasite is its ability to persist in the central nervous system (CNS).
The worldwide seroprevalence of toxoplasmosis is 25–30 % [1]; however, targeted surveillance is routinely done on pregnant and immunocompromised patients since these are the populations in which we observe the severe clinical sequelae of primary infection or reactivation including hydrops fetalis and toxoplasma encephalitis, respectively [2], [3].
In the immunocompetent individual, T. gondii infection tends to be mild or asymptomatic. CNS toxoplasmosis is mainly encountered in immunocompromised patients including those with human immunodeficiency virus infection or acquired immunodeficiency syndrome (HIV/AIDS), those with hematologic diseases, and those with solid-organ or bone marrow transplants. There have been only a few cases of CNS toxoplasmosis described in individuals who are on immunosuppressive agents for autoimmune diseases [9], [10], [11], [12], [13]. We therefore sought to report a case of CNS toxoplasmosis in a non-HIV immunosuppressed individual seen at our institution.
Case report
A 78-year-old male with a past medical history of non-Hodgkin’s lymphoma, myasthenia gravis on chronic mycophenolate mofetil (MMF), coronary artery disease, and type II diabetes mellitus presented to an emergency department in Iowa with altered mental status. The patient had previously undergone 6 cycles of chemotherapeutic treatment for stage IVA extranodal B-cell lymphoma, unclassifiable, with features intermediate between diffuse large B-cell lymphoma and classic Hodgkin lymphoma. His treatment comprised of a regimen of cyclophosphamide, doxorubicin, vincristine, and prednisone (modified CHOP therapy). He received his lymphoma diagnosis one year earlier and finished his chemotherapy six months prior to the current presentation with a near complete resolution of the lymphoma on repeat computed tomography (CT). Surveillance positron emission tomography (PET) scan obtained two months prior to current admission exhibited no evidence of disease.
The patient’s wife reported that he had begun to exhibit odd behaviors including having right-sided visual hallucinations for three weeks prior to presentation. The patient progressively worsened to the point of being unable to understand or respond appropriately to his wife, and was subsequently brought to the emergency department. While in the emergency room, he was observed to have a dry cough and an episode of emesis.
On initial examination, vital signs included a temperature of 100.5 °F, blood pressure of 151/74 mmHg, and heart rate of 87 beats per minute. The patient was oriented only to self, he did not follow any commands, and his speech was nonsensical; but he did not have any focal neurologic deficits. The remainder of his exam was normal. A non-contrast CT scan of the head showed a large area of evolving cerebral infarcts with involvement of the left frontal, parietal, and occipital lobes; there was no intracranial hemorrhage. The patient was deemed not to be a candidate for tissue plasminogen activator (tPA). With the patient’s global aphasia and history of lymphoma, there was concern for brain metastasis.
Laboratory workup was significant for a leukopenia of 3990 per μL. Respiratory viral panel was negative, chest x-ray did not show any acute cardiopulmonary process, and urinalysis was unremarkable for infection. Blood and urine cultures for bacteria and fungus were negative. HIV antigen/antibody test was non-reactive. Given abnormal CT head findings, a magnetic resonance imaging (MRI) of the brain was done and revealed peripherally enhancing lesions in the left frontal and occipital lobes (Fig. 1, Fig. 2), which was thought to be consistent with metastases. The patient was initiated on intravenous dexamethasone and referred to an oncologist for further treatment of presumed metastatic lymphoma to the brain. His mycophenolate mofetil (MMF) for his myasthenia gravis was slowly tapered given his disease was quiescent for years.
Fig. 1.
Rim enhancing lesion in the left frontal lobe with extensive surrounding vasogenic edema, associated with restricted diffusion within the brain shown with arrows in DWI [A], axial ADC [B], axial T1 [C], and FLAIR [D] sequences of MRI brain without contrast. DWI = diffusion weighted imaging; ADC = apparent diffusion coefficient; MRI = magnetic resonance imaging.
Fig. 2.
Rim enhancing lesion in the left occipital lobe with extensive surrounding vasogenic edema, associated with restricted diffusion within the brain arrows in [E], axial ADC [F], axial T1 [G], and FLAIR [H] sequences of MRI brain without contrast. DWI = diffusion weighted imaging; ADC = apparent diffusion coefficient; MRI = magnetic resonance imaging.
The patient was transferred to a tertiary care center. On admission, the oncologists and neurosurgery teams obtained a repeat MRI that showed two peripherally enhancing lesions in the left hemisphere with restricted diffusion. Additionally, there were tiny foci of enhancement in the right hemisphere. These findings were suspicious for an infectious process. He underwent an image-guided biopsy of the left frontal lobe lesion and microscopic examination revealed microorganisms consistent with Toxoplasma gondii (Fig. 3, Fig. 4). Additionally, serum testing for Toxoplasma gondii by polymerase chain reaction (PCR) was positive. Infectious diseases (ID) consultation was sought, and the patient was started on pyrimethamine PO 200 mg loading dose followed by 75 mg PO daily, sulfadiazine 1.5 g PO every six hours, and leucovorin 25 mg PO daily. The patient received levetiracetam for seizure prophylaxis as well. After treatment for cerebral toxoplasmosis was initiated, the patient’s mental status began to recover. Due to issues with medication availability and cost, he was switched to high-dose trimethoprim/sulfamethoxazole (TMP-SMX). Two days later, the patient began to exhibit dysphagia and a weak voice; stress-dose steroids were initiated with prednisone 60 mg PO daily and MMF for possible myasthenic crisis. The patient’s symptoms improved, and he was discharged to a rehabilitation facility. He initially did well at the facility, but then began to regress with loss of strength and worsening mental status. He then sustained a fall. A follow-up MRI brain showed progressive enhancing lesions with dural extension and possible bleeding. With these findings, the MMF was discontinued, and he was re-started on pyrimethamine/sulfadiazine/leucovorin. This led to clinical improvement in mentation and strength. However, the patient could not tolerate this regimen due to severe gastrointestinal side effects and was therefore switched back to high-dose TMP-SMX. MRI was repeated three weeks later, which showed persistent disease similar to the prior imaging study, along with bilateral chronic subdural hematomas that had since enlarged slightly.
Fig. 3.
Microscopic examination (magnification × 400, hematosylin and eosin stain) of a biopsy of the left frontal lobe reveals encysted forms (arrow) and multiple free tachyzoites (arrowhead). Background brain parenchyma with reactive gliosis.
Fig. 4.
Microscopic examination (magnification × 400, hematosylin and eosin stain) of an intraoperative smear preparation from the brain brain biopsy shows the protozoan forms of Toxoplasma bradyzoites within a cyst.
Two months after the patient’s initial diagnosis of cerebral toxoplasmosis, he presented to an emergency department in Ohio with altered mental status. He had decreased oral intake, a significant 40-pound weight loss, and decreased urine output. Laboratory evaluation was significant for pancytopenia and an elevated serum creatinine of 2.3 mg/dL. TMP-SMX was held, and he was fluid-resuscitated with normal saline. A CT scan of the brain showed worsening chronic subdural hematoma, which was likely the cause of the patient’s acute cognitive decline. He underwent urgent bilateral burr hole placement to evacuate the hematomas. His hospital course was complicated by aspiration pneumonia that was treated with antibiotics. Eventually, he underwent PEG-tube placement. His hospital course was further complicated by Clostridium difficile colitis, myocardial infarction, and persistent pancytopenia requiring numerous transfusions. Upon discharge, the patient was to complete 4 more weeks of clindamycin 600 mg daily and azithromycin 900 mg for CNS toxoplasmosis.
Two months after discharge, the patient returned to the emergency department due to concern for aspiration pneumonia and increasing weakness. Workup was notable for a sodium of 111 mmol/L and labs consistent with disseminated intravascular coagulation (DIC). The patient was started on vancomycin and piperacillin-tazobactam for healthcare associated pneumonia, as well as clindamycin and azithromycin for toxoplasmosis. Due to the patient’s continued hyponatremia and a worsening acidosis, he was intubated and placed on mechanical ventilation. He continued to have hemodynamic instability. Ultimately, per a goals of care discussion, he was transitioned to care geared toward comfort. He died 5 months after his initial diagnosis of cerebral toxoplasmosis.
Discussion
T. gondii was recognized as a major opportunistic pathogen during the HIV/AIDS pandemic in the 1980s. Under immunocompetent conditions, the parasitic infection remains in a chronic subclinical state. The organism can exist in cyst form in skeletal muscle, brain, myocardium, eyes, etc. However, in persons with HIV/AIDS, suppression of the immune system allows for the rupture of the cysts. This leads to the release of bradyzoites, and subsequently the conversion to the actively-dividing trophozoite stage—and significant morbidity ensues, including toxoplasma encephalitis [4]. A study by Grant et al. showed that most cases of cerebral toxoplasmosis was a result of reactivation of a previously acquired infection in HIV/AIDS populations, as illustrated by the patients’ serologic evidence of prior exposure. Antibodies to T. gondii were found in 32 % of the patients with AIDS; and of these patients, 24 % developed cerebral toxoplasmosis [5], [6].
While our patient did not have HIV/AIDS, he was on high dose immunosuppressant medication which is a risk factor for reactivation of latent T. gondii. The patient was on chronic mycophenolate mofetil (MMF), which is a selective inhibitor of lymphocyte proliferation and function [3] for myasthenia gravis (MG). Furthermore, patients with MG may be placed on high dose corticosteroids for induction and treatment of exacerbations. Maintenance therapy usually involves tapering of the corticosteroids in conjunction with the use of steroid-sparing agents including azathioprine or MMF [7].
To date, less than ten cases have been published implicating MMF in the development of cerebral toxoplasmosis in non-HIV persons (Table 1). Four of these cases involved MMF used in the setting of myasthenia gravis like our own patient, one case in pemphigus vulgaris, one in undifferentiated connective tissue disease, and one in inflammatory myopathy [3]. In one of these cases, MMF was the sole immunosuppressive agent in that patient’s regimen—which illustrates the risk posed by MMF monotherapy in the development of cerebral toxoplasmosis.
Table 1.
Cases of cerebral toxoplasmosis among non-HIV patients on immunosuppression.
| Author, year, Ref. | Age (years)/Gender | Disease | Immunosuppressant drugs | Serology and microbiology | Neuropathology | Treatment | Follow up |
|---|---|---|---|---|---|---|---|
| Savsek et al., 2014[1] | 62, F | Diffuse large B cell lymphoma, R-CHOP | R-LP (rituximab and chlorambucil), R-FC (rituximab, chlorambucil, and cyclophosphamide), and R-CHOP | Serology and blood PCR positive for T. gondii | N/A | Sulfadiazine, pyrimethamine, and folic acid for 6 weeks | Mild cognitive deficits on a 3-month follow-up; continued with prophylactic doses of Sulfadiazine, pyrimethamine, and folic acid |
| Lee et al., 2020[3] | 58, M | Myasthenia gravis, T2DM | MMF and prednisolone | Serum Toxoplasma IgG positive | Underwent 3 brain biopsies; third brain tissue specimen Toxoplasma PCR positive | Sulfadiazine, pyrimethamine, and folic acid for 6 weeks | Complete resolution after 6 weeks followed by low-dose secondary prophylaxis with Sulfadiazine, pyrimethamine, and folic acid |
| Oliveira., et al. 2018[14] | 60, F | RA and SLE | Prednisone, methotrexate, leflunomide | Positive T. gondii antibodies | Cerebral parenchymal perivascular lymphocytic pattern and suppurative areas, Toxoplasma gondii tachyzoites identified | Pyrimethamine and sulfadiazine for 7 days | Death |
| Assimakopoulos et al., 2015[8] | 33, F | Ulcerative colitis | Prednisone and azathioprine | T. gondii specific IgM positive but IgG negative. CSF Gram stain noted for pseudocyst containing bradyzoites | Not done | Pyrimethamine, folinic acid, and clindamycin for 4 weeks | Complete recovery |
|
Lee et al., 2019[11] |
52, F | Pemphigus Vulgaris | MMF, prednisone, azathioprine, and rituximab | Plasma-based next generation sequencing assay (Karius test) was positive for cell-free Toxoplasma DNA | Not done | Pyrimethamine and leucovorin for 6 weeks, later to TMP-SMX for 6 weeks | Complete recovery; TMP-SMX once daily as maintenance |
| Sasson et al., 2016[12] | 54, F | Myasthenia Gravis, Thymoma with Good’s syndrome | MMF | Non-contributory | Brain tissue biopsy showed toxoplasmosis and PCR | Sulfadiazine, pyrimethamine | Improved; on sulfadiazine, pyrimethamine and atovaquone at last follow up |
| Singer et al., 2018[13] | 70, F | Myasthenia Gravis | MMF, prednisone | Serum T. gondii IgG positive, CSF T. gondii PCR positive | Not done | Pyrimethamine, leucovorin, clindamycin (due to sulfa allergy) for 6 weeks; after 6 weeks transitioned to atovaquone and doses of pyrimethamine and leucovorin reduced | Stable, on therapy at last follow up |
| Bernardo et al., 2015[9] | Case 1: 77, M. Case 2: 72, F | Myasthenia Gravis (case 1). Inflammatory myopathy (case 2) | Both patients on long-term MMF and prednisone. Case 2 also received rituximab | Case 1: serum IgM and IgG were positive for T. gondii. CSF T. gondii B1 gene RT-PCR was positive. Case 2: serum IgG for T. gondii positive but IgM negative. CSF T. gondii B1 gene RT-PCR was positive | Not done | Both cases received pyrimethamine, sulfadiazine, and leucovorin for 2 months | Case 1: died. Case 2: died |
| Pistacchi et al., 2016[10] | 48, F | Undifferentiated CTD with polymyositis | Prednisone and MMF | Positive toxoplasma IgG antibodies | Biopsy of the lesions not performed when alive. Postmortem findings: microscopic examination revealed widespread microglial nodules, containing bradyzoites and tachyzoites of Toxoplasma gondii | Pyrimethamine and sulfadiazine | At day 11 of therapy, patient died |
| Our case | 78, M | NHL, Myasthenia gravis, T2DM | Modified CHOP therapy, MMF, IV dexamethasone, and prednisone | Serum T. gondii PCR was positive | Left frontal lobe lesion biopsy positive for T. gondii | Initially pyrimethamine, sulfadiazine, leucovorin, transitioned to TMP-SXZ due to cost issues and also GI side effects, clindamycin and azithromycin (due to AKI and pancytopenia) | Died 5 months after his initial diagnosis of CNS toxoplasmosis |
To our knowledge, our patient was on no other immunosuppressant agents at home. However, his history of extranodal unclassified B-cell lymphoma complicates his immune status. Incidence of various infections of the central nervous system is up to 15 % in patients with malignancies, and T. gondii is among the most prevalent [1]. But, as of six months prior to presentation, our patient had completed six cycles of chemotherapy with cyclophosphamide, doxorubicin, vincristine, and prednisone (modified CHOP therapy) and was determined cancer-free. So, when he presented with neurological deficits and peripherally enhancing lesions on MRI, CNS lymphoma was among the top differential diagnoses and it can be very difficult to distinguish from cerebral toxoplasmosis. Multiple lesions of subcortical location and an asymmetric target sign on standard MRI are features suggestive of cerebral toxoplasmosis. On PET scan, the standardized uptake for CNS lymphoma lesions is much higher than in lesions from toxoplasmosis [1]. Diagnosis of cerebral toxoplasmosis can prove difficult solely with imaging as not every patient will exhibit the characteristic ring-enhancing lesions and edema. A definitive diagnosis requires a biopsy of the affected tissue with demonstration of T. gondii microorganisms [8]. This was demonstrated in our patient who had an MRI guided brain biopsy with cerebral tissue showing T. gondii (Fig. 3, Fig. 4).
It should be noted that in patients with hematologic malignancies, there are very rare reports of toxoplasmosis; this rate increases marginally with bone marrow transplant recipients but is still very uncommon. There have been very few reports of cerebral toxoplasmosis in patients on the chemotherapeutic agents that our patient had previously received, and these infections occurred while the patient was on active treatment and not following the cessation of treatment as in the case of our patient. Cerebral toxoplasmosis was most closely tied to the use of rituximab which is part of the R-CHOP regimen [1]. However, our patient was on a modified regimen that did not include rituximab. Chemoprophylaxis for T. gondii is important to consider in patients on any immunosuppressive therapy for malignancy or autoimmune conditions. At this time, no specific screening guidelines for latent toxoplasmosis prior to administering immunosuppressants exist [1], [9]; the utility in doing so requires future study.
Conclusion
Toxoplasmosis has a high global prevalence, yet cerebral toxoplasmosis has only been rarely reported in patients with hematologic malignancies or in those receiving immunosuppressive agents. There needs to be a high degree of suspicion for T. gondii in HIV-negative individuals who are on immunosuppressants including MMF. More studies need to be done to ascertain optimal testing strategies in this population and to evaluate the utility of chemoprophylaxis in the prevention of reactivation.
CRediT authorship contribution statement
Rachel King: major contribution in chart abstraction and writing discussion. Poorani Sekar: major contribution discussion and overall editing of manuscript. Henna Patel: contribution in chart abstraction. Maryam Naveed: editing and helping with submission process. Sumaia Aqtash: contribution in reviewing chart. Shubham Adroja: obtained publication quality radiographs. Denise Jacob: obtained pathology slides and photomicrographs. Talha Riaz: overall editing, guidance and coordination.
Funding
None.
Ethical approval
Obtained.
Consent
Obtained from the patient’s son.
Conflict of Interest
All authors - no COI.
Contributor Information
Maryam Naveed, Email: mnaveed@arizona.edu, naveedmaryam01@gmail.com.
Talha Riaz, Email: riazt@email.arizona.edu, talhariaz240@gmail.com.
References
- 1.Savsek L., Opaskar T.R. Cerebral toxoplasmosis in a diffuse large B cell lymphoma patient. Radiol Oncol. 2016;50(1):87–93. doi: 10.1515/raon-2014-0042. [PMID: 27069454; PMCID: PMC4825343] [DOI] [PMC free article] [PubMed] [Google Scholar]
- 2.Mendez O.A., Koshy A.A. Toxoplasma gondii: entry, association, and physiological influence on the central nervous system. PLoS Pathog. 2017;13(7) doi: 10.1371/journal.ppat.1006351. [PMID: 28727854; PMCID: PMC5519211] [DOI] [PMC free article] [PubMed] [Google Scholar]
- 3.Lee M, Sethi K, Guy E. Toxoplasmosis: an overlooked cause of confusion in a patient with myasthenia gravis. Clin Infect Pract. Vol. 7. 100022. 〈 10.1016/j.clinpr.2020.100022〉. [DOI]
- 4.Kamerkar S., Davis P.H. Toxoplasma on the brain: understanding host-pathogen interactions in chronic CNS infection. J Parasitol Res. 2012;2012 doi: 10.1155/2012/589295. [Epub 2012 Mar 22. PMID: 22545203; PMCID: PMC3321570] [DOI] [PMC free article] [PubMed] [Google Scholar]
- 5.Grant I.H., Gold J.W., Rosenblum M., Niedzwiecki D., Armstrong D. Toxoplasma gondii serology in HIV-infected patients: the development of central nervous system toxoplasmosis in AIDS. AIDS. 1990;4(6):519–521. [PMID: 2386617] [PubMed] [Google Scholar]
- 6.Kodym P., Malý M., Beran O., Jilich D., Rozsypal H., Machala L., et al. Incidence, immunological and clinical characteristics of reactivation of latent Toxoplasma gondii infection in HIV-infected patients. Epidemiol Infect. 2015;143(3):600–607. doi: 10.1017/S0950268814001253. [Epub 2014 May 22. PMID: 24850323; PMCID: PMC9507066] [DOI] [PMC free article] [PubMed] [Google Scholar]
- 7.Richman D.P., Agius M.A. Treatment of autoimmune myasthenia gravis. Neurology. 2003;61(12):1652–1661. doi: 10.1212/01.wnl.0000098887.24618.a0. [PMID: 14694025] [DOI] [PubMed] [Google Scholar]
- 8.Assimakopoulos S.F., Stamouli V., Dimitropoulou D., Spiliopoulou A., Panos G., Anastassiou E.D., et al. Toxoplasma gondii meningoencephalitis without cerebral MRI findings in a patient with ulcerative colitis under immunosuppressive treatment. Infection. 2015;43(5):589–593. doi: 10.1007/s15010-015-0730-9. [Epub 2015 Jan 27. PMID: 25623638] [DOI] [PubMed] [Google Scholar]
- 9.Bernardo D.R., Jr, Chahin N. Toxoplasmic encephalitis during mycophenolate mofetil immunotherapy of neuromuscular disease. Neurol Neuroimmunol Neuroinflamm. 2015;22(2):e63. doi: 10.1212/NXI.0000000000000063. [(1). PMID: 25635260; PMCID: PMC4309524] [DOI] [PMC free article] [PubMed] [Google Scholar]
- 10.Pistacchi M., Gioulis M., Zirillo M., Francavilla E., Zambito, Marsala S. Cerebral toxoplasmosis in undifferentiated connective disease treated with mycophenolate mofetil: an unusual case report. Acta Neurol Belg. 2016;116(4):633–636. doi: 10.1007/s13760-015-0595-9. [Epub 2016 Jan 12. PMID: 26754114] [DOI] [PubMed] [Google Scholar]
- 11.Lee E.B., Ayoubi N., Albayram M., Kariyawasam V., Motaparthi K. Cerebral toxoplasmosis after rituximab for pemphigus vulgaris. JAAD Case Rep. 2019;6(1):37–41. doi: 10.1016/j.jdcr.2019.10.015. [PMID: 31909136; PMCID: PMC6938870] [DOI] [PMC free article] [PubMed] [Google Scholar]
- 12.Sasson S.C., Davies S., Chan R., Davies L., Garsia R. Cerebral toxoplasmosis in a patient with myasthenia gravis and thymoma with immunodeficiency/Good's syndrome: a case report. BMC Infect Dis. 2016;16(1):457. doi: 10.1186/s12879-016-1801-y. [PMID: 27576953; PMCID: PMC5004299] [DOI] [PMC free article] [PubMed] [Google Scholar]
- 13.Singer J.L., Pena N.D.L. Toxoplasma gondii encephalitis from mycophenolate mofetil: a case report and review. Arch Med. 2018;10(5) doi: 10.21767/1989-5216.1000286. [DOI] [Google Scholar]
- 14.Oliveira M.F.D., Pereira C.B., SilvaI V.B., Costa M.C., Paes V.R., Ibrahim R.E. Rapid progression of neurotoxoplasmosis in a patient with concomitant rheumatoid arthritis and systemic lupus erythematous. MedicalExpress. 2018:5. doi: 10.5935/MedicalExpress.2018.ml.002. [DOI] [Google Scholar]